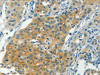
The image on the left is immunohistochemistry of paraffin-embedded Human liver cancer tissue using CSB-PA168970 (CHRNA2 Antibody) at dilution 1/30, on the right is treated with synthetic peptide. (Original magnification: ×200) The image on the left is immunohistochemistry of paraffin-embedded Human liver cancer tissue using CSB-PA168970 (CHRNA2 Antibody) at dilution 1/30, on the right is treated with synthetic peptide. (Original magnification: ×200)

Cusabio Polyclonal Antibodies
CHRNA2 Antibody | CSB-PA168970
- SKU:
- CSB-PA168970
- Availability:
- 3 to 7 Working Days
Description
CHRNA2 Antibody | CSB-PA168970 | Cusabio
CHRNA2 Antibody is Available at Gentaur Genprice with the fastest delivery.
Online Order Payment is possible or send quotation to info@gentaur.com.
Product Type: Polyclonal Antibody
Target Names: CHRNA2
Aliases: cholinergic receptor, nicotinic, alpha 2 (neuronal)
Background: Nicotinic acetylcholine receptors (nAChRs) are ligand-gated ion channels formed by a pentameric arrangement of alpha and beta subunits to create distinct muscle and neuronal receptors. Neuronal receptors are found throughout the peripheral and central nervous system where they are involved in fast synaptic transmission. This gene encodes an alpha subunit that is widely expressed in the brain. The proposed structure for nAChR subunits is a conserved N-terminal extracellular domain followed by three conserved transmembrane domains, a variable cytoplasmic loop, a fourth conserved transmembrane domain, and a short C-terminal extracellular region. Mutations in this gene cause autosomal dominant nocturnal frontal lobe epilepsy type 4. Single nucleotide polymorphisms (SNPs) in this gene have been associated with nicotine dependence.
Isotype: IgG
Conjugate: Non-conjugated
Clonality: Polyclonal
Uniport ID: Q15822
Host Species: Rabbit
Species Reactivity: Human
Immunogen: Synthetic peptide of human CHRNA2
Immunogen Species: Human
Applications: ELISA, IHC
Tested Applications: ELISA, IHC;ELISA:1:2000-1:5000, IHC:1:25-1:100
Purification Method: Antigen affinity purification
Dilution Ratio1: ELISA:1:2000-1:5000
Dilution Ratio2: IHC:1:25-1:100
Dilution Ratio3:
Dilution Ratio4:
Dilution Ratio5:
Dilution Ratio6:
Buffer: -20°C, pH7.4 PBS, 0.05% NaN3, 40% Glycerol
Form: Liquid
Storage: Upon receipt, store at -20°C or -80°C. Avoid repeated freeze.
Initial Research Areas: Neuroscience
Research Areas: Neuroscience